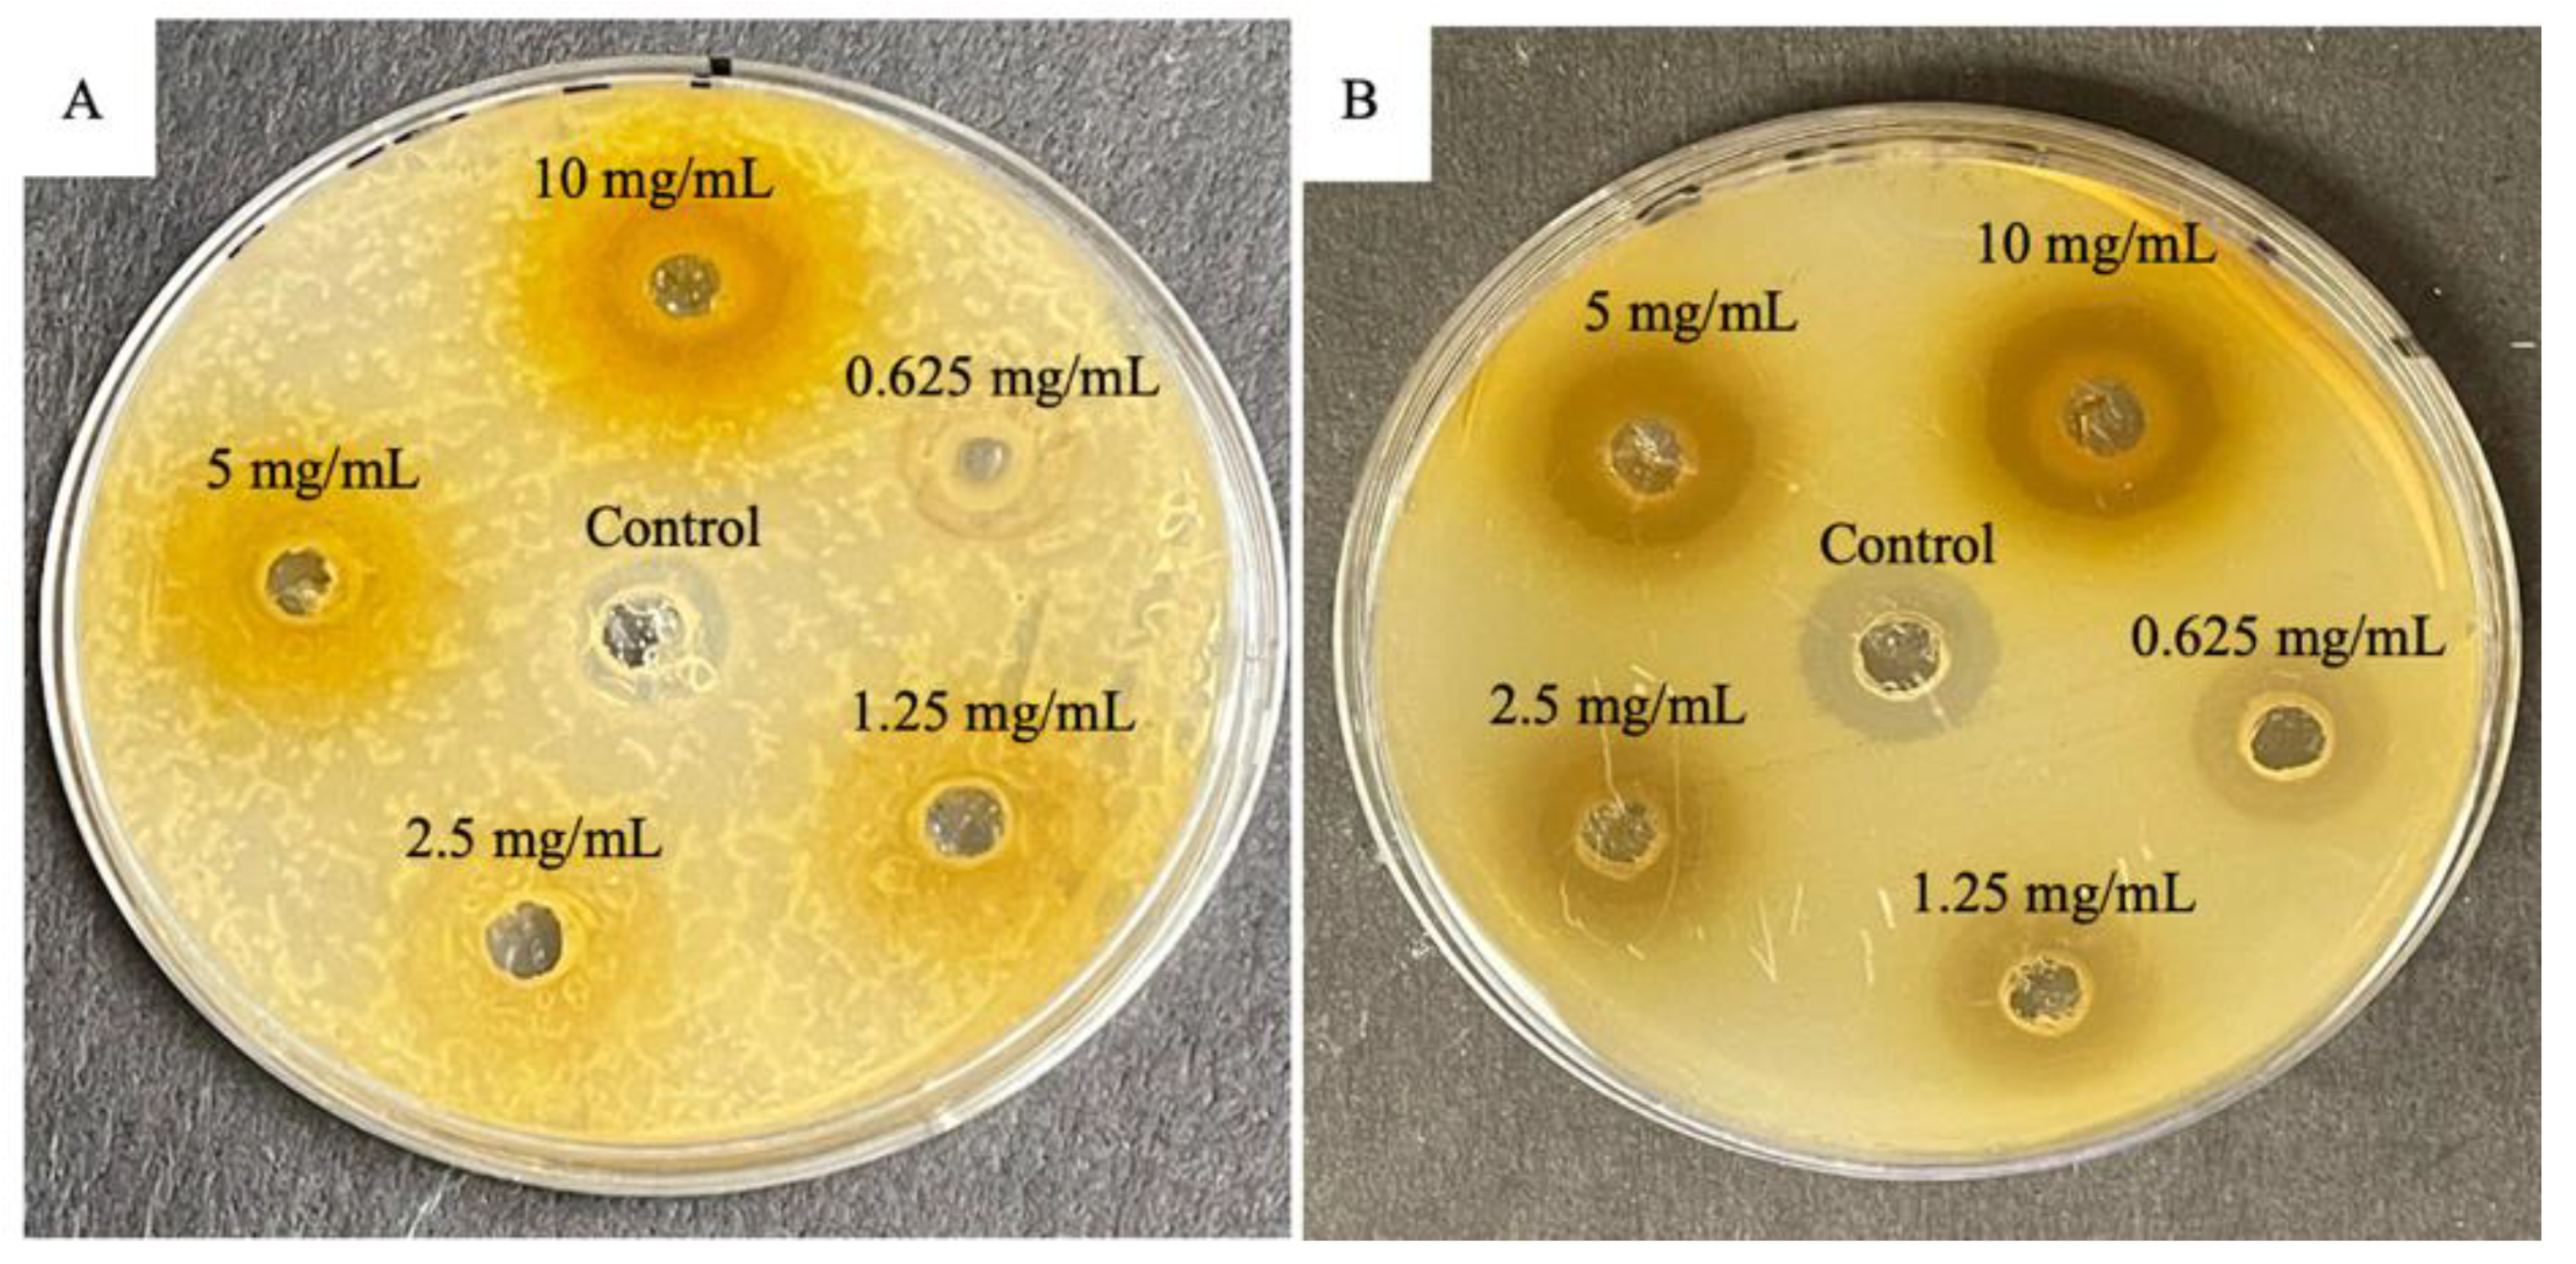
Horticulturae 08 00909 g002 Horticulturae 08 00909 g002

Phytochemical Screening, and Antibacterial and Antioxidant Activities of Mangifera indica L. Leaves
Abstract
1. Introduction
2. Materials and Methods
2.1. Collection and Identification of Plant Materials
2.2. Preparation of Leaf Extracts
2.3. Phytochemical Screening
2.4. In Vitro Antibacterial Assay
2.5. In Vitro Antioxidant Assay: DPPH Free Radical Scavenging Activity
- Abs control is the absorbance of DPPH and methanol;
- Abs sample is the absorbance of the DPPH radical + sample.
2.6. Statistical Analysis
3. Results and Discussion
3.1. Percentage Yield and Phytochemical Screening
3.2. Antibacterial Activity
3.3. In Vitro Antioxidant Activity
4. Conclusions
Author Contributions
Funding
Institutional Review Board Statement
Informed Consent Statement
Data Availability Statement
Acknowledgments
Conflicts of Interest
References
- Sharif, M.D.M.; Banik, G.R. Status and utilization of medicinal plants in Rangamati of Bangladesh. Res. J. Agric. Biol. Sci. 2006, 2, 268–273. [Google Scholar]
- Kubmarawa, D.; Ajoku, G.A.; Enwerem, N.M.; Okorie, D.A. Preliminary phytochemical and antimicrobial screening of 50 medicinal plants from Nigeria. Afr. J. Biotechnol. 2007, 6, 90–1696. [Google Scholar]
- Lamboro, T.; Ketema, T.; Bacha, K. Prevalence and antimicrobial resistance in Salmonella and Shigella species isolated from outpatients, Jimma University Specialized Hospital, Southwest Ethiopia. Can. J. Infect. Dis. Med. Microbiol. 2016, 2016, 4210760. [Google Scholar] [CrossRef]
- Chatterji, D.; Petchiappan, A. Antibiotic resistance: Current perspectives. ACS Omega 2017, 2, 7400–7409. [Google Scholar]
- Tower, S.J.; Hetcher, W.J.; Myers, T.E.; Kuehl, N.J.; Taylor, M.T. Selective modification of tryptophan residues in peptides and proteins using a biomimetic electron transfer process. J. Am. Chem. Soc. 2020, 142, 9112–9118. [Google Scholar] [CrossRef] [PubMed]
- Streicher, J.M.; Liktor-Busa, E.; Keresztes, A.; LaVigne, J.; Largent-Milnes, T.M. Analgesic potential of terpenes derived from Cannabis sativa. Pharmacol. Rev. 2021, 73, 98–126. [Google Scholar]
- Dzotam, J.K.; Kuete, V. Antibacterial and antibiotic-modifying activity of methanol extracts from Six cameroonian food plants against multidrug-resistant enteric bacteria. BioMed Res. Int. 2017, 2017, 1583510. [Google Scholar] [CrossRef] [PubMed]
- Kumar, M.; Saurabh, V.; Tomar, M.; Hasan, M.; Changan, S.; Sasi, M.; Mekhemar, M. Mango (Mangifera indica L.) leaves: Nutritional composition, phytochemical profile, and health-promoting bioactivities. Antioxidants 2021, 10, 299. [Google Scholar] [CrossRef]
- Kasote, D.M.; Katyare, S.S.; Hegde, M.V.; Bae, H. Significance of antioxidant potential of plants and its relevance to therapeutic applications. Int. J. Biol. Sci. 2015, 11, 982–991. [Google Scholar] [CrossRef]
- Yoo, S.; Kim, K.; Nam, H.; Lee, D. Discovering health benefits of phytochemicals with integrated analysis of the molecular network, chemical Properties and ethnopharmacological evidence. Nutrients 2018, 10, 1042. [Google Scholar] [CrossRef]
- Aslam, B.; Wang, W.; Arshad, M.I.; Khurshid, M.; Muzammil, S.; Rasool, M.H.; Nisar, M.A.; Alvi, R.F.; Aslam, M.A.; Qamar, M.U.; et al. Antibiotic resistance: A rundown of a global crisis. Infect. Drug Resist. 2018, 11, 1645–1658. [Google Scholar] [CrossRef] [PubMed]
- Alam, S.B.; Mahmud, M.; Akter, R.; Hasan, M.; Sobur, A.; Nazir, K.N.H.; Noreddin, A.; Rahman, T.; El Zowalaty, M.E.; Rahman, M. Molecular detection of multidrug resistant Salmonella Species isolated from broiler farm in Bangladesh. Pathogens 2020, 9, 201. [Google Scholar] [CrossRef] [PubMed]
- Rupasinghe, H.P.V.; Balasuriya, N.; Wang, Y. Prevention of type 2 diabetes by polyphenols of fruits. In Nutritional Antioxidant Therapies: Treatments and Perspectives; Springer: Cham, Switzerland, 2017; pp. 447–466. [Google Scholar]
- Bouyahya, A.; Et-Touys, A.; Bakri, Y.; Talbaui, A.; Fellah, H.; Abrini, J.; Dakka, N. Chemical composition of Mentha pulegium and Rosmarinus officinalis essential oils and their antileishmanial, antibacterial and antioxidant activities. Microb. Pathog. 2017, 111, 41–49. [Google Scholar] [CrossRef] [PubMed]
- Khan, N.; Bano, A.; Zandi, P. Effects of exogenously applied plant growth regulators in combination with PGPR on the physiology and root growth of chickpea (Cicer arietinum) and their role in drought tolerance. J. Plant Interact. 2018, 13, 239–247. [Google Scholar] [CrossRef]
- Erhabor, C.; Erhabor, J.; McGaw, L. The potential of South African medicinal plants against microbial biofilm and quorum sensing of foodborne pathogens: A review. S. Afr. J. Bot. 2019, 126, 214–231. [Google Scholar] [CrossRef]
- Qais, F.A.; Shafiq, A.; Khan, H.M.; Husain, F.M.; Khan, R.A.; Alenazi, B.; Ahmad, I. Antibacterial effect of silver nanoparticles synthesized using Murraya koenigii (L.) against multidrug-resistant pathogens. Bioinorg. Chem. Appl. 2019, 2019, 4649506. [Google Scholar] [CrossRef]
- Tan, A.C.; Ashley, D.M.; López, G.Y.; Malinzak, M.; Friedman, H.S.; Khasraw, M. Management of glioblastoma: State of the art and future directions. CA A Cancer J. Clin. 2020, 70, 299–312. [Google Scholar] [CrossRef]
- Verma, P.; Verma, R.K. Succession of culturable microbes on rhizospheres soil of iron ore mined overburden dump in Dalli Rajhara, Durg, Chhattisgarh, India. Plant Arch. 2019, 19, 1179–1189. [Google Scholar]
- Guha, B.; Arman, M.; Islam, M.N.; Tareq, S.M.; Rahman, M.M.; Sakib, S.A.; Alqahtani, A.M. Unveiling pharmacological studies provide new insights on Mangifera longipes and Quercus gomeziana. Saudi J. Biol. Sci. 2021, 28, 183–190. [Google Scholar] [CrossRef]
- Tegen, D.; Dessie, K.; Damtie, D. Candidate Anti-COVID-19 Medicinal Plants from Ethiopia: A review of plants traditionally used to treat viral diseases. Evid.-Based Complement. Altern. Med. 2021, 2021, 6622410. [Google Scholar] [CrossRef]
- Ainane, A.; Cherroud, S.; El Kouali, M.; Abba, E.H.; Ainane, T. Chemical compositions, insecticidal and antimicrobial activities of two moroccan essential oils of Citrus limonum and Syzygium aromaticum. Pharmacol. J. 2020, 30, 190–199. [Google Scholar]
- Abdoul-Latif, F.M.; Elmi, A.; Merito, A.; Nour, M.; Risler, A.; Ainane, A.; Ainane, T. Essential Oils of Tagetes minuta and Lavandula coronopifolia from Djibouti: Chemical Composition, Antibacterial Activity and Cytotoxic Activity against Various Human Cancer Cell Lines. Int. J. Plant Biol. 2022, 13, 315–329. [Google Scholar] [CrossRef]
- Nuthakki, V.K.; Mudududdla, R.; Sharma, A.; Kumar, A.; Bharate, S.B. Synthesis and biological evaluation of indoloquinoline alkaloid cryptolepine and its bromo-derivative as dual cholinesterase inhibitors. Bioorganic Chem. 2019, 90, 103062. [Google Scholar] [CrossRef]
- Nafiqoh, N.; Zairin, M.; Lusiastuti, A.; Sarter, S.; Caruso, D.; Avarre, J.C. Antimicrobial properties against Aeromonas hydrophila and immunostimulant effect on Clarias gariepinus of Piper betle, Psidium guajava, and Tithonia diversifolia plants. Aquac. Int. 2020, 28, 1–13. [Google Scholar] [CrossRef]
- Akwu, N.A.; Naidoo, Y.; Singh, M. Cytogenotoxic and biological evaluation of the aqueous extracts of Grewia lasiocarpa: An Allium cepa assay. S. Afr. J. Bot. 2019, 125, 371–380. [Google Scholar] [CrossRef]
- Harborne, J.B. Photochemical Methods: A Guide to Modern Techniques of Plant Analysis; Chapman & Hall: London, UK, 1973. [Google Scholar]
- Trease, G.E.; Evans, W.C. Pharmacology, 11th ed.; Bailliere Tindall Ltd.: London, UK, 1978. [Google Scholar]
- Sofowora, A. Medicinal Plants and Traditional Medicines in Africa; Chichester John Wiley & Sons: New York, NY, USA, 1993. [Google Scholar]
- Tiwari, P.; Kumar, B.; Kaur, M.; Kaur, G.; Kaur, H. Phytochemical screening and extraction: A review. Int. Pharm. Sci. 2011, 1, 98–106. [Google Scholar]
- Karthikeyan, A.; Senthil, N.; Min, T. Nanocurcumin: A promising candidate for therapeutic applications. Front. Pharmacol. 2020, 11, 487. [Google Scholar] [CrossRef]
- Perez, C.; Paul, M.B.P. Antibiotic assay by agar-well diffusion method. Acta Biol. Med. Exp. 1990, 15, 113–115. [Google Scholar]
- Mani, M.; Okla, M.K.; Selvaraj, S.; Kumar, A.R.; Kumaresan, S.; Muthukumaran, A.; Elshikh, M.S. A novel biogenic Allium cepa leaf mediated silver nanoparticle for antimicrobial, antioxidant, and anticancer effects on MCF-7 cell line. Environ. Res. 2021, 198, 111199. [Google Scholar] [CrossRef]
- Braca, A.; Sortino, C.; Politi, M.; Morelli, I.; Mendez, J. Antioxidant activity of flavonoids from Licanialicaniaeflora. J. Ethnopharmacol. 2002, 79, 379–381. [Google Scholar] [CrossRef]
- Moradi, M.; Mateu Cronie, O.J. Inhomogeneous higher-order summary statistics for point processes on linear networks. Stat. Comput. 2020, 30, 1221–1239. [Google Scholar]
- Omokhua, A.G.; Abdalla, M.A.; Van Staden, J.; McGaw, L.J. A comprehensive study of the potential phytomedicinal use and toxicity of invasive Tithonia species in South Africa. BMC Complement. Altern. Med. 2018, 18, 272. [Google Scholar] [CrossRef] [PubMed]
- Oladeji, O. The characteristics and roles of medicinal plants: Some important medicinal plants in Nigeria. Nat. Prod. Indian J. 2016, 12, 102. [Google Scholar]
- Dowlath Hus, M.J.; Kumar, K.S.; DarulRaiyaan, G.I.; Khalith, S.B.M.; Sundarapandian, S.; Deivi, A.K. Effect of solvents on phytochemical composition and antioxidant activity of Cardiospermum halicacabum (L.) extracts. Pharmacogn. J. 2020, 12, 1241–1251. [Google Scholar] [CrossRef]
- Mohammed, A.H.; Náinna, S.Z.; Yusháu, M.; Salisu, B.; Adamu, U.; Garba, S.A. Phytochemical screening and antibacterial activity of Mangifera indica extracts. UMYU J. Microbiol. Res. 2016, 1, 23–28. [Google Scholar]
- Ruther, J.; Meiners, T.; Steidle, J.L.M. Allelochemical Reactions Involving Heterotrophic Microorganisms. Biogeochem. Inland Waters 2010, 22, 436–438. [Google Scholar]
- Geetha, B.; Gowda, K.P.; Kulkarni, G.T.; Badami, S. Microwave assisted fastextraction of mucilages and pectins. Indian J. Pharm. Educ. Res. 2009, 43, 260–265. [Google Scholar]
- Sungthongjeen, S.; Pitaksuteepong, T.; Somsiri, A.; Sriamornsak, P. Studies on pectins as potential hydrogel matrices for controlled-release drug delivery. Drug Dev. Ind. Pharm. 1999, 25, 1271–1276. [Google Scholar] [CrossRef]
- Babu, H.R.; Savithramma, N. Screening of secondary metabolites of underutilized species of Cyperaceae. Int. J. Pharm. Sci. Res. 2014, 24, 182–187. [Google Scholar]
- Rabi, T.; Bishayee, A. Terpenoids and breast cancer chemoprevention. Breast Cancer Res. Treat. 2009, 115, 223–239. [Google Scholar] [CrossRef]
- Yadav, R.N.S.; Agarwala, M. Phytochemical analysis of some medicinal plants. J. Phytol. 2011, 3, 10–14. [Google Scholar]
- Krishnaiah, D.; Devi, T.; Bono, A.; Sarbatly, R. Studies on phytochemical constituents of six Malaysian medicinal plants. J. Med. Plants Res. 2009, 3, 67–72. [Google Scholar]
- Shah, B.A.; Qazi, G.N.; Taneja, S.C. Boswellic acids: A group of medicinally important compounds. Nat. Prod. Rep. 2009, 26, 72–89. [Google Scholar] [CrossRef] [PubMed]
- Doss, A. Preliminary phytochemical screening of some Indian medicinal plants. Anc. Sci. Life 2009, 29, 12. [Google Scholar] [PubMed]
- Joona, K.; Sowmia, C.; Dhanya, K.P.; Divya, M.J. Preliminary phytochemical investigation of Mangifera indica leaves and screening of antioxidant and anticancer activity. RJPBCS 2013, 4, 1112–1118. [Google Scholar]
- Rakholiya, K.; Chanda, S. Pharmacognostic, Physicochemical and Phytochemical Investigation of Mangifera indica L. var. Kesar leaf. Asian Pac. J. Trop. Biomed. 2012, 2, 680–684. [Google Scholar] [CrossRef]
- Masud, P.G.M. Pharmacological activities of mango (Mangifera indica): A review. J. Pharmacogn. Phytochem. 2016, 5, 1–7. [Google Scholar]
- Kabir, Y.; Shekhar, H.U.; Sidhu, J.S. Phytochemical compounds in functional properties of mangoes. In Handbook of Mango Fruit; Wiley: Hoboken, NJ, USA, 2017; pp. 237–254. [Google Scholar]
- Guo, L.; Gong, S.; Wang, Y.; Sun, Q.; Duo, K.; Fei, P. Antibacterial Activity of Olive Oil Polyphenol Extract against Salmonella Typhimurium and Staphylococcus aureus: Possible Mechanisms. Foodborne Pathog. Dis. 2020, 17, 396–403. [Google Scholar] [CrossRef]
- Sengstock, C.; Lopian, M.; Motemani, Y.; Borgmann, A.; Khare, C.; Buenconsejo, P.J.S.; Köller, M. Structure-related antibacterial activity of a titanium nanostructured surface fabricated by glancing angle sputter deposition. Nanotechnology 2014, 25, 195101. [Google Scholar] [CrossRef]
- India, S.J.; Ray, P.; Manchanda, V.; Bajaj, J.; Chitnis, D.S.; Gautam, V.; Indian Network for Surveillance of Antimicrobial Resistance (INSAR) group. Methicillin resistant Staphylococcus aureus (MRSA) in India: Prevalence & susceptibility pattern. Indian J. Med. Res. 2013, 137, 363. [Google Scholar]
- Jeeva, S.; Johnson, M.; Aparna, J.S.; Irudayaraj, V. Preliminary phytochemical and antibacterial studies on flowers of selected medicinal plants. Int. J. Med. Aromat. Plants 2011, 1, 107–114. [Google Scholar]
- Choudhary, R.K.; Swarnkar, P.L. Antioxidant activity of phenolic and flavonoid compounds in some medicinal plants of India. Nat. Prod. Res. 2011, 25, 1101–1109. [Google Scholar] [CrossRef] [PubMed]
- Shukla, A.; Parmar, P.; Patel, B.; Goswami, D.; Saraf, M. Breaking Bad: Better call gingerol for improving antibiotic susceptibility of Pseudomonas aeruginosa by inhibiting multiple quorum sensing pathways. Microbiol. Res. 2021, 252, 126863. [Google Scholar] [CrossRef] [PubMed]
- Teka, A.; Rondevaldova, J.; Asfaw, Z.; Demissew, S.; Van Damme, P.; Kokoska, L.; Vanhove, W. In vitro antimicrobial activity of plants used in traditional medicine in Gurage and Silti Zones, south central Ethiopia. BMC Complement. Altern. Med. 2015, 15, 286. [Google Scholar] [CrossRef]
- Mazlan, N.A.; Azman, S.; Ghazali, N.F.; Yusri, P.Z.S.; Idi, H.M.; Ismail, M.; Sekar, M. Synergistic antibacterial activity of mangiferin with antibiotics against Staphylococcus aureus. Drug Invent. Today 2019, 12, 14–17. [Google Scholar]
- Krishnananda, K.K.; Shabaraya, A.R. Comparison of antibacterial activity of leaves extracts of Tectona grandis, mangifera Indica, and Anacardium Occidentale. Int. J. Pharmacol. Res. 2017, 9, 36–39. [Google Scholar]
- Diso, S.; Ali, M.; Mukhtar, S.; Garba, M. Antibacterial activity and phytochemical screening of Mangifera indica (Mango) stem and leaf extracts on clinical isolates of methicillin resistant Staphylococcus aureus. J. Adv. Med. Pharm. Sci. 2017, 13, 1–6. [Google Scholar] [CrossRef]
- Sanrawal, A.; Sushil, K. Antibacterial activity of MI leaves against drug resistant bacteria strain. Int. J. Adv. Res. 2013, 1, 82–86. [Google Scholar]
- Seleshe, S.; Kang, S.N. In vitro antimicrobial activity of different solvent extracts from Moringa stenopetala leaves. Prev. Nutr. Food Sci. 2019, 24, 70. [Google Scholar] [CrossRef]
- Cudjoe, E.; Donu, D.; Okonu, R.E.; Amponsah, J.A.; Amoah, L.E. The in vitro antiplasmodial activities of aqueous extracts of selected Ghanaian herbal plants. J. Parasitol. Res. 2020, 2020, 5041919. [Google Scholar] [CrossRef]
- Ramasar, R.; Naidoo, Y.; Dewir, Y.H.; El-Banna, A.N. Seasonal Change in Phytochemical Composition and Biological Activities of Carissa macrocarpa (Eckl.) A. DC. Leaf Extract. Horticulturae 2022, 8, 780. [Google Scholar] [CrossRef]
- Delcour, A.H. Outer membrane permeability and antibiotic resistance. Biochim. Et Biophys. Acta (BBA)-Proteins Proteom. 2009, 1794, 808–816. [Google Scholar] [CrossRef] [PubMed]
- Flaxman, S.; Mishra, S.; Gandy, A. Estimating the effects of non-pharmaceutical interventions on COVID-19 in Europe. Nature 2020, 584, 257–261. [Google Scholar] [CrossRef] [PubMed]
- Breijyeh, Z.; Jubeh, B.; Karaman, R. Resistance of gram-negative bacteria to current antibacterial agents and approaches to resolve it. Molecules 2020, 25, 1340. [Google Scholar] [CrossRef]
- Dauner, M.; Skerra, A. Scavenging bacterial siderophores with engineered lipocalin proteins as an alternative antimicrobial strategy. Chembiochem Eur. J. Chem. Biol. 2020, 21, 601–606. [Google Scholar] [CrossRef]
- Tavassoli-Kafrani, E.; Gamage, M.V.; Dumée, L.F.; Kong, L.; Zhao, S. Edible films and coatings for shelf-life extension of mango: A review. Crit. Rev. Food Sci. Nutr. 2020, 62, 2432–2459. [Google Scholar] [CrossRef] [PubMed]
- Zhang, J.; Terrones, M.; Park, C.R.; Mukherjee, R.; Monthioux, M.; Koratkar, N.; Bianco, A. Carbon science in status, challenges, and perspectives. Carbon 2016, 98, 708–732. [Google Scholar] [CrossRef]
- Sridharan, M.; Kamaraj, P.; Vennila, R.; Huh, Y.S.; Arthanareeswari, M. Bio-inspired construction of melanin-like polydopamine-coated CeO2 as a high-performance visible-light-driven photocatalyst for hydrogen production. New J. Chem. 2020, 44, 15223–15234. [Google Scholar] [CrossRef]
- Kumar, Y.; Kumar, V.S. Comparative antioxidant capacity of plant leaves and herbs with their antioxidative potential in meat system under accelerated oxidation conditions. J. Food Meas. Charact. 2020, 14, 3250–3262. [Google Scholar] [CrossRef]
- Mohan, C.G.; Deepak, M.; Viswanatha, G.L.; Savinay, G.; Hanumantharaju, V.; Rajendra, C.E.; Halemani, P.D. Anti-oxidant and anti-inflammatory activity of leaf extracts and fractions of Mangifera indica. Asian Pac. J. Trop. Med. 2013, 6, 311–314. [Google Scholar] [CrossRef]
- Itoh, K.; Matsukawa, T.; Okamoto, M.; Minami, K.; Tomohiro, N.; Shimizu, K.; Kajiyama, S.; Endo, Y.; Matsuda, H.; Shigeoka, S. In vitro antioxidant activity of Mangifera indica leaf extracts. J. Plant Stud. 2020, 9, 39. [Google Scholar] [CrossRef]
- Herrera, F.; Mitchell, J.D.; Pell, S.K.; Collinson, M.E.; Daly, D.C.; Manchester, S.R. Fruit morphology and anatomy of the Spondioid Anacardiaceae. Bot. Rev. 2018, 84, 315–393. [Google Scholar] [CrossRef] [PubMed]
- Kumar, S.; Sandhir, R.; Ojha, S. Evaluation of antioxidant activity and total phenol in different varieties of Lantana camara leaves. BMC Res. Notes 2014, 7, 560. [Google Scholar] [CrossRef]
- Manjula, M.S.; Ganthi, A.S. In-vitro antioxidant and anti-inflammatory potential of ethanol extracts (root and aerial parts) of Mangifera indica. Ann. Plant Sci. 2018, 7, 1997–2001. [Google Scholar]
- Tepe, B.; Eminagaoglu, O.; Akpulat, H.A.; Aydin, E. Antioxidant potentials and rosmarinic acid levels of the methanolic extracts of Salvia verticillata (L.) subsp. verticillata and S. verticillata (L.) subsp. amasiaca (Freyn & Bornm.) Bornm. Food Chem. 2007, 100, 985–989. [Google Scholar]
- Patel, S.; Wilson, R.; Dawood, A.; Foschi, F.; Mannocci, F. The detection of periapical pathosis using digital periapical radiography and cone beam computed tomography—Part 2: A 1year post treatment follow up. Int. Endod. J. 2012, 45, 711–723. [Google Scholar] [CrossRef]
- Amoo, S.O.; Finnie, J.F.; Van Staden, J. The role of meta-topolins in alleviating micropropagation problems. Plant Growth Regul. 2011, 63, 197–206. [Google Scholar] [CrossRef]
- Nithitanakool, S.; Pithayanukul, P.; Bavovada, R. Antioxidant and hepatoprotective activities of Thai mango seed kernel extract. Planta Med. 2009, 75, 1118–1123. [Google Scholar] [CrossRef]
- Dhital, K.S. Phytochemical screening and antioxidant activities of Mangifera indica leaves grown in temperate region of Nepal. J. Pharmacogn. Phytochem. 2017, 6, 205–209. [Google Scholar]
- Houghton, R.A.; Butman, D.; Bunn, A.G.; Krankina, O.N.; Schlesinger, P.; Stone, T.A. Mapping Russian forest biomass with data from satellites and forest inventories. Environ. Res. Lett. 2007, 2, 045032. [Google Scholar] [CrossRef]
- Kumari, A.; Parida, A.K.; Rangani, J.; Panda, A. Antioxidant activities, metabolic profiling, proximate analysis, mineral nutrient composition of Salvadora persica fruit unravel a potential functional food and a natural source of pharmaceuticals. Front. Pharmacol. 2017, 8, 61. [Google Scholar] [CrossRef] [PubMed]
- Born, M.; Carrupt, P.A.; Zini, R.; Bree, F.; Tillement, J.P.; Hostettmann, K. Electrochemical behavior and antioxidant activity of some natural polyphenols. Helv. Chim. Acta 1996, 79, 1147–1158. [Google Scholar] [CrossRef]
- Ocampo, E.T.M.; Libron, J.A.M.A.; Guevarra, M.L.D.; Mateo, J.M.C. Phytochemical screening, phenolic acid profiling and antioxidant activity analysis of peels from selected mango (Mangifera spp.) genotypes in the Philippines. Food Res. 2020, 4, 1116–1124. [Google Scholar] [CrossRef]
- Xu, S.; Li, J.L.; Zhang, X.Q.; Wei, H.; Cui, L.J. Effects of heat acclimation pretreatment on changes of membrane lipid peroxidation, antioxidant metabolites, and ultrastructure of chloroplasts in two cool-season turfgrass species under heat stress. Environ. Exp. Bot. 2006, 56, 274–285. [Google Scholar] [CrossRef]
- Vermani, K.; Garg, S. Herbal medicines for sexually transmitted diseases and AIDS. J. Ethnopharmacol. 2002, 80, 49–66. [Google Scholar] [CrossRef]

| Solvent | Summer Leaves | Winter Leaves | Summer Leaves | Winter Leaves |
|---|---|---|---|---|
| Dried Extract Yield (g) | Percentage Yield (%) | |||
| Hexane | 0.82 | 0.45 | 8.2 | 5.5 |
| Chloroform | 0.98 | 0.77 | 9.8 | 7.7 |
| Methanol | 2.7 | 2.33 | 27 | 23.3 |
| Test | Summer Extracts | Winter Extracts | ||||
|---|---|---|---|---|---|---|
| Hexane | Chloroform | Methanol | Hexane | Chloroform | Methanol | |
| Alkaloid tests | ||||||
| + | + | + | + | + | + |
| + | + | + | + | + | + |
| Phenols, tannins, flavonoids, and quinones tests | ||||||
| (i) Ferric chloride test | ++ | + | + | ++ | + | + |
| (ii) Lead acetate test | + | ++ | +++ | + | ++ | +++ |
| (iii) Gelatin test | +++ | ++ | − | +++ | +++ | − |
| Flavonoid test | ||||||
| (i) Alkaline reagent test (alkaline hydrolysis) | ++ | + | +++ | ++ | + | +++ |
| (ii) Acid hydrolysis (sulphuric acid) | +++ | + | + | +++ | + | + |
| Terpene test | ||||||
| (a) Saponins | ||||||
| (i) Foam test | − | − | + | − | − | + |
| (b) Steroids | ||||||
| (i) Liebermann–Burchard test or acetic anhydride test | + | − | + | + | − | + |
| (ii) Salkowski’s test | + | + | + | + | + | + |
| Carbohydrate test | ||||||
| (i) Molisch’s test | + | + | + | + | + | + |
| Protein test | ||||||
| (i) Ninhydrin test | − | − | − | − | − | − |
| (ii) Biuret test | +++ | − | + | +++ | − | + |
| Gum and mucilage test | ||||||
| (i) Precipitation test | + | + | + | + | + | + |
| (ii) Ruthenium red test | − | +++ | + | − | ++ | + |
| (iii) Detection of resins | + | − | − | + | − | − |
| Bacterial Strain | Concentrations (mg/mL) and Diameter of Zone of Inhibition (mm) | |||||
|---|---|---|---|---|---|---|
| 0.625 | 1.25 | 2.5 | 5 | 10 | Control | |
| Summer | ||||||
| Staphylococcus aureus (ATCC 43300) | 7.5 ± 0.5 | 8.83 ± 0.76 | 9.83 ± 076 | 11.50 ± 1.32 | 14.17 ± 0.29 | 13.67 ± 0.76 |
| Escherichia coli (ATCC 25922) | 9.17 ± 1.76 | 11.17 ± 1.04 | 14.33 ± 0.58 | 16.33 ± 1.15 | 18.5 ± 0.5 | 17.5 ± 1.5 |
| Winter | ||||||
| Staphylococcus aureus (ATCC 43300) | 6.83 ± 0.29 | 7.67 ± 0.58 | 8.83 ± 0.76 | 10.67 ± 0.58 | 12.33 ± 0.58 | 13.33 ± 0.76 |
| Escherichia coli (ATCC 25922) | 6.25 ± 0.35 | 6.67 ± 1.15 | 7.17 ± 1.15 | 7.67 ± 1.61 | 8.5 ± 1.32 | 14.5 ± 3.04 |
| Extraction Solvents (IC50—μg/mL) | |||
|---|---|---|---|
| Seasons | Hexane | Chloroform | Methanol |
| Summer | 19.53 | 70.13 | 12.71 |
| Winter | 22.32 | 93.08 | 14.35 |
| Ascorbic acid | 3.20 | ||
Publisher’s Note: MDPI stays neutral with regard to jurisdictional claims in published maps and institutional affiliations. |
© 2022 by the authors. Licensee MDPI, Basel, Switzerland. This article is an open access article distributed under the terms and conditions of the Creative Commons Attribution (CC BY) license (https://creativecommons.org/licenses/by/4.0/).
Share and Cite
Maharaj, A.; Naidoo, Y.; Dewir, Y.H.; Rihan, H. Phytochemical Screening, and Antibacterial and Antioxidant Activities of Mangifera indica L. Leaves. Horticulturae 2022, 8, 909. https://doi.org/10.3390/horticulturae8100909
Maharaj A, Naidoo Y, Dewir YH, Rihan H. Phytochemical Screening, and Antibacterial and Antioxidant Activities of Mangifera indica L. Leaves. Horticulturae. 2022; 8(10):909. https://doi.org/10.3390/horticulturae8100909
Chicago/Turabian StyleMaharaj, Arvish, Yougasphree Naidoo, Yaser Hassan Dewir, and Hail Rihan. 2022. "Phytochemical Screening, and Antibacterial and Antioxidant Activities of Mangifera indica L. Leaves" Horticulturae 8, no. 10: 909. https://doi.org/10.3390/horticulturae8100909
APA StyleMaharaj, A., Naidoo, Y., Dewir, Y. H., & Rihan, H. (2022). Phytochemical Screening, and Antibacterial and Antioxidant Activities of Mangifera indica L. Leaves. Horticulturae, 8(10), 909. https://doi.org/10.3390/horticulturae8100909

